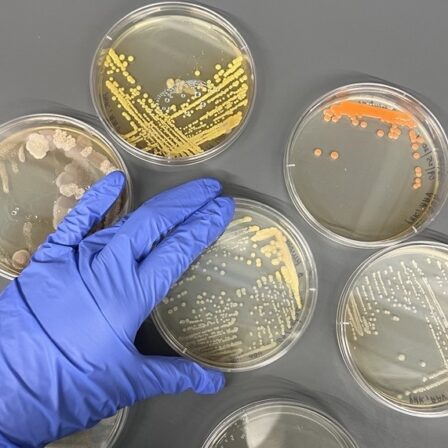

Microbiology is the study of organisms too small to be seen with the naked eye, including bacteria and archaea, as well as many fungi and protists. In the Wet Lab Makerspace, we have the equipment and consumables necessary to cultivate, manipulate, and quantify many types of microorganisms. In addition to the Open Lab, where work is limited to Risk Group 1 organisms, we also have a Microbiology Room, in which trained users may cultivate Risk Group 2 organisms. We also maintain a strain library which users may access for approved projects.
In the Wet Lab Makerspace, we stock consumables and reagents that are commonly used across most projects, but not those that are specific to a single project or hypothesis. For microbiology, we stock one line of plastic consumables that fit our instruments, reagents to make common microbial growth media, and few commonly used antibiotics. We also maintain a strain library which users may access for approved projects. Any strains, antibiotics, or other consumables not currently stocked, must be ordered on a project-by-project basis.